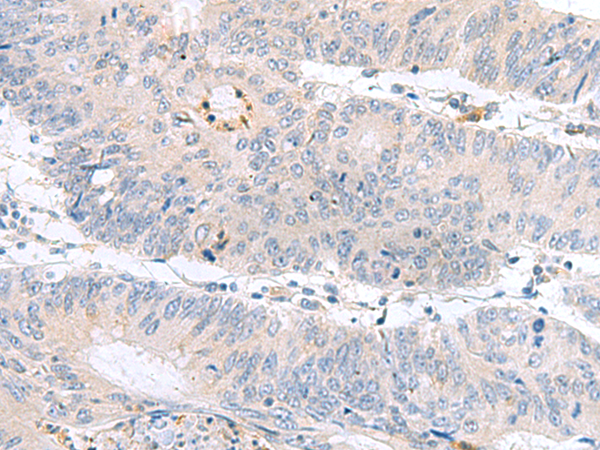

-
分类: 科研抗体货号: P03172别名: SEN2; PCH2B; SEN2L应用: WB,IHC反应种属: Human, Mouse, Rat
-
分类: 科研抗体货号: P03169别名: GK2应用: IHC反应种属: Human, Mouse, Rat
-
分类: 科研抗体货号: P03262别名: JCLN; JCLN1; ZG16A应用: WB,IHC反应种属: Human, Mouse
-
分类: 科研抗体货号: P03168别名: C20orf162应用: WB,IHC反应种属: Human, Mouse
-
分类: 科研抗体货号: P03322别名: HSPC137应用: IHC反应种属: Human, Mouse
-
分类: 科研抗体货号: P03259别名: CPXIII; CPX-III; Nbla11589应用: WB,IHC反应种属: Human, Mouse, Rat
-
分类: 科研抗体货号: P03165别名: TYW2; TRM12应用: WB,IHC反应种属: Human, Rat
-
分类: 科研抗体货号: P03319别名: DQB2; HLA-DXB; HLA-DQB1应用: IHC反应种属: Human
-
分类: 科研抗体货号: P03254别名: PDED; JBTS22应用: WB,IHC反应种属: Human, Mouse
-
分类: 科研抗体货号: P03164别名: PPS; SKIP; MDCCAID应用: WB,IHC反应种属: Human, Mouse

鄂公网安备42018502007531号
鄂公网安备42018502007531号

